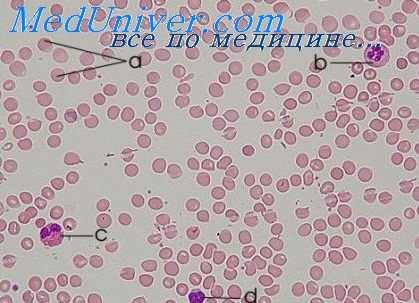
иммунология бронхиальной астмы

Наследственные причины аллергий. Генетика атопий
Добавил пользователь Алексей Ф. Обновлено: 11.12.2025
Как вам уже известно, аллергия — это повышенная чувствительность к различным веществам при прямом контакте с ними, проявляющаяся неадекватной реакцией организма. Сегодня аллергия занимает первое место в рейтинге наиболее распространенных заболеваний. В чем же причина аллергии у детей и взрослых?
Аллергены — причина возникновения аллергии
Причиной аллергической реакции являются аллергены — генетически чужеродные вещества, имеющие антигенную природу. Уже сейчас известно их более 10 тысяч. А более 20 тысяч веществ являются потенциальными аллергенами. В роли аллергенов может быть все, что нас окружает. Исключением является дистиллированная вода.
Для одних людей причиной аллергии является домашняя пыль либо плесень, солнечные лучи либо холод. Тогда как для других — пыльца растений либо шерсть животных, пищевые продукты либо лекарственные препараты. В последние десятилетия распространенность аллергических проявлений стремительно растет.
Аллергены, как правило, выступают в роли триггеров. Они способствуют первичному появлению признаков и симптомов аллергии, вызывают обострение болезни, то есть способствуют развитию аллергической реакции.
Почему отмечается динамика ее роста и с чем это связано? Оказалось, что природа аллергии загадочна. Но, тем не менее, общепризнанной остается теория, что в основе аллергии лежит нарушение реактивности иммунной системы человеческого организма.
Единого мнения в этиологии аллергии и факторах, способствующих изменению реактивности иммунной системы, пока нет. Хотя мнения многих специалистов сходятся на том, что ведущую роль в создании дисбаланса иммунных механизмов играют определенные факторы.
Наследственная предрасположенность — атопия. В ответ на повторный контакт с причинными аллергенами организм генетически предрасположен к образованию антител — нарушается регуляция иммунного ответа. При наличии аллергии у одного из родителей, риск для ребенка составляет в пределах 40%. Тогда как наличие двух родителей-аллергиков повышает риск до 100%. В редких случаях возникает аллергия у людей, не обладающих наследственной предрасположенностью.
Макроэкология
В развитии аллергии виновны загрязнители атмосферы. Это окись азота и серы, озон, которые ухудшают экологическую обстановку. Глобальное потепление продлевает сезон пыления растений, а значит, продолжительность контакта с пыльцевыми аллергенами увеличивается. Микроэкология тоже ухудшается. Не в лучшую сторону изменяются условия быта, ухудшается качество воды и пищевых продуктов. Появляются генно-модифицированные продукты, а также всевозможные красители, ароматизаторы, стабилизаторы, консерванты.
Основа аллергической реакции
Для развития аллергической реакции необходимо три составляющих: организм с наследственной предрасположенностью; провоцирующие факторы, создающие благоприятные условия для реализации такой предрасположенности; контакт с причинным аллергеном.
Провоцирующие факторы
Провоцирующие факторы создают благоприятные условия для появления аллергических симптомов. Причины аллергии у взрослых более обширны, нежели у детей.
Функциональные нарушения в работе желудочно-кишечного тракта повышают вероятность развития пищевой аллергии, на, казалось бы, обычные продукты питания. За сутки каждый человек сталкивается со 120 пищевыми аллергенами. И только при определенных условиях возникает аллергическая реакция. Это может быть переедание, когда поступает большое количество аллергенов. Воспалительные заболевания органов пищеварения, наличие паразитов в пищеварительном тракте, дисбактериоз значительно повышают риск развития аллергических признаков.
Нарушение очистительной функции печени. Почечная недостаточность, что нарушает выделительную функцию почек. Аутоаллергены проявляют свое негативное влияние при нарушении работы печени и почек, при инфаркте миокарда. В некоторых случаях даже хрусталик глаза может вызвать аллергическую реакцию. Имеет аллергия и психологические причины.
У людей, имеющих предрасположенность к аллергии, достаточно высока вероятность развития гиперчувствительности к другим аллергенам.
Наследственные причины аллергий. Генетика атопий
Существует наследственная предрасположенность к атопическим заболеваниям. Однако при таких заболеваниях, как бронхиальная астма, диффузный нейродермит и аллергический ринит, в развитии которых взаимодействуют наследственные и средовые факторы, крайне трудно выделить роль определенных генов. Клиническая картина при этих заболеваниях, по всей вероятности, определяется сложным взаимодействием многих генетических локусов, и характерная для любой атопической болезни вариабельность фенотипа зависит от изменений в каждом из этих локусов. Ситуация еще более осложняется тем, что разные аллергические заболевания могут иметь одни и те же генетические маркеры. Например, атопию часто выявляют по немедленной реакции на внутрикожное введение аллергенов и повышенному уровню IgE в крови, тогда как бронхиальная астма характеризуется повышенной реактивностью дыхательных путей.
В основе аллергических заболеваний лежат изменения по крайней мере двух групп генов. Одни из них контролируют системные проявления атопии, общие для различных аллергических заболеваний (например, повышение синтеза IgE и эозинофилию), а другие определяют местные воспалительные реакции в отдельных органах-мишенях (например, в коже при диффузном нейродермите или в легких при бронхиальной астме). Исследование генома больных диффузным нейродермитом выявили ассоциацию этого заболевания с изменением в хромосомах lq21,3q21, 17q25 и 20р. Эти участки тесно связаны с известными локусами псориаза. Локус lq21 содержит кластер генов, влияющих на дифференцировку эпидермиса.
Главные подходы к выявлению генов, ответственных за атопические болезни, включают 1) идентификацию генов-кандидатов, основанную на поиске полиморфизмов, способных изменять функцию или экспрессию известных генов, продукты которых участвуют в патогенезе атопии или воспаления; 2) позиционное клонирование специфических областей хромосомы, ассоциированных с наследованием болезни. Физическое картирование этих областей позволяет идентифицировать локализованные в них гены. Затем гены-кандидаты исследуют на предмет наличия мутаций или специфических полиморфизмов. Известно несколько генов-кандидатов, ассоциированных с атопическими болезнями. Сцепление и значительную ассоциацию с атопическими заболеваниями обнаруживают отдельные аллели генов на хромосомах 5, 6, 11, 12 и 14.

Хромосома 5. Сегмент 5q23-35 содержит несколько генов, возможно, причастных к патогенезу аллергических заболеваний. К ним относятся тены, кодирующие цитокины Тh2-клеток (ИЛ-3, ИЛ-4, ИЛ-5, ИЛ-9, ИЛ-13 и ГМ-КСФ). В качестве кандидата особенно подробно исследован ген ИЛ-4. Замена цитозина на тимидин в положении 589 промоторной области гена ИЛ-4 приводит к появлению необычного сайта связывания фактора транскрипции NF-AT (ядерный фактор активированных Т-клеток), повышению сродства его связывания, усилению транскрипции гена ИЛ-4 и возрастанию продукции IgE. Это согласуется с важной ролью ИЛ-4 в развитии Тh2-клеток и переключении синтеза классов иммуноглобулинов на синтез IgE. К другим генам этой хромосомы, способным влиять на развитие аллергических реакций, относятся гены синтазы лейкотриена С4, гены рецептора М-ГСФ, глюкокортикоидного рецептора и b2-адренорецептора.
Хромосома 6. На этой хромосоме расположены гены, кодирующие HLA I и II классов, которые регулируют специфичность и интенсивность иммунного ответа на специфические аллергены. Здесь локализованы и гены, играющие центральную роль в процессе распознавания и представления антигенов, в том числе гены транспортеров, участвующих в обработке антигенов (ТАР). Реакции IgE на специфические аллергены (такие, как антиген амброзии Amb a V и аллерген пылевого клеща Der p 1) сцеплены с определенными локусами HLA класса II. На хромосоме 6 находится и ген ФНО-а — главного цитокина, участвующего в привлечении клеток в очаг воспаления. Найдена ассоциация полиморфизмов гена ФНО-а с бронхиальной астмой.
Хромосома 11. Рядом исследований доказана связь атопии с сегментом Hql3. В качестве расположенного здесь гена-кандидата рассматривается ген, кодирующий |3-субъединицу высокоаффинного рецептора IgE (FceRI-b), которая ускоряет проведение внутриклеточного сигнала от этого рецептора. Обнаружена ассоциация нескольких генетических вариантов FceRI-b с бронхиальной астмой, повышенной реактивностью бронхов и диффузным нейродермитом.
Хромосома 12. Бронхиальная астма и другие атопические заболевания связаны и с особенностями хромосомы 12. На ее длинном плече локализуется ряд генов-кандидатов — ИФН-у, NO-синтазы, ФСК, STAT-6, ИФР-1 и b-субъединицы ядерного фактора-Y. ИФН-у способствует развитию Тh1-клеток и угнетает функцию Тh2-клеток; STAT-6 активируется ИЛ-4 и принимает участие в индукции переключения синтеза иммуноглобулинов на синтез IgE и дифференцировке Тh2-клеток, а ФСК поддерживает пролиферацию и дифференцировку тучных клеток.
Другие хромосомы. На хромосоме 14 локализован ген ос-цепи TCR, которая играет важную роль в распознавании аллергенов. Обнаружена выраженная ассоциация реакций IgE на ряд аллергенов и общего уровня IgE в сыворотке крови с некоторыми ос-изотипами TCR, свидетельствующая о роли этого гена в модификации специфических реакций IgE. Найдена также связь между атопией и усиливающим функцию полиморфизмом гена а-субъединицы рецептора ИЛ-4, который расположен на хромосоме 16. Имеются данные и о связи бронхиальной астмы с сегментами 17р12—qll.2, где локализованы гены, кодирующие хемокины RANTES и эотаксин, которым принадлежит основная роль в привлечении эозинофилов в дыхательные пути при бронхиальной астме.
Гены могут влиять на течение аллергических заболеваний и иными путями, определяя, например, эффективность лечения кортикостероидами, b2-адреномиметиками и средствами, изменяющими метаболизм лейкотриенов. По некоторым данным, присутствие глутамата в положении 27 b2-адренорецептора ассоциировано с меньшей реактивностью дыхательных путей при бронхиальной астме. Присутствие глицина в положении 16 этого рецептора ассоциировано с ночным падением ОФВ1. Полиморфизм промотора гена 5-липоксигеназы сказывается на синтезе лейкотриенов. Наконец, полиморфизм промотора гена ИЛ-4 с ускорением его транскрипции ассоциирован с резистентностью к кортикостероидам и тяжелым течением бронхиальной астмы. В связи с этим следует отметить, что совместное воздействие ИЛ-2 и ИЛ-4 придает Т-лимфоцитам резистентность к кортикостероидам.
Иммунология бронхиальной астмы. Генетические основы атопии и астмы
В 1916 г. Cooke и Vandor Veer изучили сенсибилизацию к человеческому белку 621 больного с астмой, вероятно, вызванной контактом с животными, сенной лихорадкой, связанной с сезоном созревания пыльцы, уртикарией, желудочно-кишечными расстройствами и ангионевротическим отеком, по всей вероятности, связанными с приемом различных пищевых продуктов. Авторы отметили положительный семейный анамнез у 48% больных, а также установили, что при наследовании с обеих сторон, т. е. от отца и матери, симптомы аллергии обычно появляются в более раннем возрасте.
На основании детальных документальных данных они предположили, что лица с аллергией могут сенсибилизироваться к некоторым белкам, с которыми часто имеют контакт ввиду своего образа жизни и внешней среды. Coca и Cooke (1923) предложили термин «атопия» для таких индивидов (по гречески странный или необычный). Coca и Grove (1925) обнаружили специфически реагирующие вещества в сыворотке лиц с атопией, которые можно было обнаружить при пассивном переносе [Prausnitz, Kustner, 1921], и назвали их «атопическим реагином».
Было доказано, что эти сывороточные факторы лабильны при нагревании, не преципитируются, специфичны и обладают длительной устойчивой способностью пассивно сенсибилизировать кожу. После того как реагиновые антитела были обнаружены и изучены в миеломном белке, теперь их считают IgE [Ishizaka et al., 1966; Johansson et al., 1968a; ВОЗ, 1968].
Pepys (1975) предложил повое определение атонии: «Та форма иммунологической реактивности, при которой реагииовые антитела (теперь известные как антитела IgE) легко образуются в ответ на обычный контакт с широко распространенными аллергенами в окружающей среде». Иммунологическая идентификация атопии у разных больных может быть основана на кожных пробах или серологии. Таким образом, атонический статус индивида определяется по его иммунологической реактивности, однако эта реактивность не всегда связана с клиническими симптомами.
Генетические основы атонии и астмы
Несмотря па детальные исследования Cooke и Vander Veer (1916) и Schwartz (1952), генетические основы атонии и астмы пока не полностью установлены. Существует точная корреляция между атоническим статусом (согласно кожным пробам) у больных астмой и частотой сенной лихорадки и экземы у их родственников I степени родства. Molina (1976) предполагал, что при поражении обоих родителей клиническая аллергия в той или иной форме развивается примерно у 00% лиц, а при наличии симптомов аллергии только у одного из родителей — у 27 %. Однако корреляция между атоническим статусом и семейной заболеваемостью астмой менее точна [Parrot, Saidelle, 1902].
Это соответствует данным работы Schwartz (1952) и нашим собственным наблюдениям (Pinerua, Turner-Warwick, неопубликованные данные 1975 г.). Однако установлено, что семейная заболеваемость атопическими клипйческими расстройствами, т. е. сенной лихорадкой и экземой, менее выражена у больных астмой с отрицательными кожными пробами («эндогенная» астма). Интересно, что частота семейной астмы была одинакова как у больных с экзогенной, так и с эндогенной астмой. Таким образом, можно полагать, что наследственные факторы, от которых зависит атопический статус, отличаются от факторов, определяющих лабильность бронхов.
Konig и Godfrey (1973) изучали лабильность бронхов при помощи нагрузочных проб у 65 родственников I степени родства 12 детей, больных астмой, и обнаружили повышенную лабильность бронхов у 8 (32%) из 25 здоровых родственников.
Информация на сайте подлежит консультации лечащим врачом и не заменяет очной консультации с ним.
См. подробнее в пользовательском соглашении.
Аллергия и наследственность: особенность общая, последствия разные
Известно ли вам, что «дыхательная» аллергия у родителей, может проявиться атопическим дерматитом у ребенка? Какова вероятность передачи «гена» аллергии? И чем сенсибилизация отличается от аллергии?
«Ген» аллергии
Термин «аллергия» впервые ввел в использование венский педиатр Клеменс фон Пирке еще в 1906 году, для обозначения необычной реакции некоторых детей на введение противодифтерийной сыворотки.
Название «аллергия» было заимствовано им из древнегреческого, и переводится буквально как «действую по-другому». В этом и заключается суть аллергии: иммунная система начинает защищаться от нейтральных, и даже полезных, для большинства людей веществ. А в основе такой гиперреактивности в 85% случаев лежит генетическая особенность.
Исследования последних лет пока не смогли убедительно доказать «вину» какого-то одного гена в развитии аллергии, и на сегодня «группа подозреваемых» насчитывает около 150 вариантов. Среди которых 40 – встречаются значительно чаще других.
Здесь и гены, кодирующие особенности барьерной функции эпителия (например, FLG, участвующий в развитии атопии), и цитокины, и многие другие.
А вероятность наследования одного из таких генов достигает 40-45%, если только один родитель страдает от аллергии, и до 75-80% - если оба.
Нельзя исключать и случайные мутации генов ребенка от «аллерго»-здоровых родителей. Правда вероятность появления аллергии при таких условиях не превышает 15%.
Аллергия или сенсибилизация
По своей сути, аллергия – защитная реакция иммунитета. Правда направлена такая защита на обычно безопасные объекты окружающей среды.
Кроме того, в отличие от других защитных механизмов, первая встреча с «непонравившимся» веществом вызывает только формирование «воспоминаний» - антител IgE. А реакция, как таковая, разворачивается «во всей красе» только при повторной и последующих встречах с аллергеном.
Наличие таких «неприятных воспоминаний» и называется сенсибилизацией, и отражает готовность организма выдать аллергическую реакцию.
Чем больше концентрация IgE к объекту, тем больше сенсибилизация и выше риск яркой аллергической реакции.
Например, если насморк, кашель и чихание возникают:
- в помещениях, где имеется плесень (угловые комнаты, балконы, под обоями, в ванной комнате) – стоит проверить уровень IgE к плесневым грибам;
- в определенный сезон года (весной, летом, осенью) – к сорным и злаковым травам, а также деревьям, цветение которых совпадает с аллергией;
- сразу после сна – оценить IgE к клещу перинному, пуху или перьям подушек (гусиное, утиное и другие).
Анализ актуален и для продуктов питания, правда с некоторой оговоркой – большинство продуктов имеют поликомпонентный состав.
Так, в составе даже «чистых» видов шоколада присутствуют следовые концентрации орехов, молока, глютена и некоторых других веществ. А любая выпечка – это микст из дрожжей, зерновых культур, яиц и других компонентов.
Кроме того, за один прием пищи, большинство людей, употребляют сразу несколько видов продуктов, а значит и «угадать» на какой из них «пошла» аллергия – чаще всего крайне сложно.
В этом случае можно использовать панели из наиболее распространенных аллергенов. Например, аллергокомплекс пищевой RIDA-screen №3, включающий наиболее аллергенных представителей практически всех пищевых групп (овощи, фрукты, морепродукты, орехи, мука и другие). Или панели по группам – овощи, фрукты, орехи, рыбы, мясо и другие.
Передается ли аллергия?
Слово «аллергия» образовалось в результате объединения греческих слов «allos» (другое) и «ergon» (работа), то есть в вольном переводе оно означает «работает по-другому». Фактически это состояние, при котором организм воспринимает некоторые вещества из внешнего мира как вредные, даже если они практически безвредны по своей природе.
Аллергическое воспаление
Аллергенами обычно являются белки как растительного, так и животного происхождения. Здоровый человек хорошо переносит эти белки, в то время как человек, страдающий аллергией, реагирует на их присутствие аллергической (или гиперчувствительной, чрезмерной) реакцией.
Специалист видит в аллергии, прежде всего, процесс, который может повредить как отдельные органы, так и весь организм. Это связано с тем, что гиперчувствительная реакция повреждает ткани, в которых она имеет место, обычно слизистые оболочки и кожу. Это состояние называется аллергическим воспалением и чаще всего обнаруживается на слизистых оболочках дыхательных путей (ринит, бронхиальная астма), на коже (например, под изображением известной экземы или классической крапивницы) или в пищеварительном тракте (затем следует ожидать анорексии, рвоты, боли и особенно аллергию).
Аллергия и генетика
Для вспышки аллергического заболевания необходимы два безошибочных фактора. Внутренний фактор — наследственный, а внешний фактор — пусковой. Аллергия имеет генетическую основу. Но будьте осторожны, даже у полностью здоровых родителей может быть ребенок с аллергией, гены путаются только при слиянии яйцеклетки со спермой, это примерно у 10% детей. Однако, если отец страдает аллергией, риск заболевания возрастает до 40%, а у матери, страдающей аллергией, риск аллергического заболевания ребенка увеличивается до 50%. И если оба родителя страдают каким-либо аллергическим заболеванием, то необходимо учитывать будущую аллергию их детей от 70 до 100%.
Атопический ген
Носитель генов аллергических заболеваний является атопическим. Это слово произошло снова из греческого языка «атопос» (необычный, подозрительный). Следовательно, атопия — это наследственная тенденция к развитию аллергии. Но атопия не обязательно означает болезнь, это просто предрасположенность. Атопик реагирует на присутствие аллергенов своей защитой, говоря очень простыми словами, он производит антитела против аллергенов — соответственно, аллергические антитела. Это иммуноглобулины, обозначаемые заглавной буквой E.
У трех из четырех пациентов с атопией в течение жизни развивается классическое аллергическое заболевание. И процент атопиков — а значит, и аллергиков — во всем мире неуклонно растет. В то время как в середине прошлого века количество атопиков составляло всего несколько процентов, сегодня их насчитывается невероятное количество — 40%, так что простым пересчетом у нас есть 30% аллергиков в человеческой популяции. Это касается и нас, поэтому у каждого третьего человека аллергическая реакция, соответственно.
Источники аллергенов
Источниками белковых аллергенов являются:
- пыльцевые зерна;
- клещи — сами тела или только их экскременты;
- животные — аллергены волос, но также их перхоть, слюна, стул, моча и т.д.;
- уличные и домашние грибы — соответственно.
Нельзя забывать об опасных источниках:
- аллергенах насекомых — ядах, слюне и экскрементах;
- пищевых аллергенах, в том числе добавках;
- лекарствах;
- химии повседневной жизни — косметике, стирке, чистке и других аптеках, клея, лака;
- и, наконец, что не менее важно, это микроорганизмы, как инфекционные, так и неинфекционные — бактерии, вирусы и паразиты.
Таким образом, список очень широкий, но аллергию могут вызывать только около 0,2% всех известных в природе белков. Эти белки — триггеры аллергических заболеваний — могут попадать в организм при вдыхании, проглатывании, контакте или прямом проникновении в кожу (укусы насекомых, инъекции и т.д.).
Читайте также:
- Обезболивание слизистых новокаином. Препараты для местной анестезии
- Канальцевая реабсорбция и секреция. Характеристика канальцевой реабсорбции
- Паралич диафрагмы при пневмотораксе. Двусторонний искусственный паралич диафрагмы
- Конституциональные болезни. Адаптационные болезни. Анемия у больного.
- Показания для операции при рассекающем остеохондрите локтевого сустава
